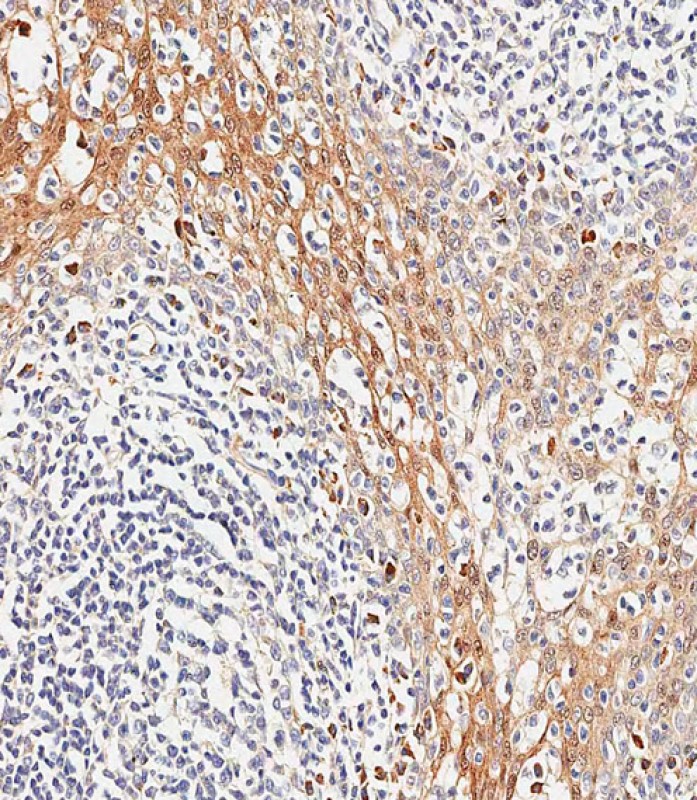

-
分类: 科研抗体货号: P34690别名: TSC22 domain family protein 3, DSIP-immunoreactive peptide, Protein DIP, hDIP, Delta sleep-inducing peptide immunoreactor, Glucocorticoid-induced leucine zipper protein, GILZ, TSC-22-like protein, TSC-22-related protein, TSC-22R, TSC22D3, DSIPI, GILZ应用: WB,IHC反应种属: Human, Mouse, Rat
-
分类: 科研抗体货号: P34702别名: Cyclin-dependent kinase inhibitor 3, CDK2-associated dual-specificity phosphatase, Cyclin-dependent kinase interactor 1, Cyclin-dependent kinase-interacting protein 2, Kinase-associated phosphatase, CDKN3, CDI1, CIP2, KAP应用: WB,IHC反应种属: Human, Mouse, Rat
-
分类: 科研抗体货号: P34689别名: CG4494-PA; LD07775p; Smt3; Ubiquitin-like protein SMT3应用: WB反应种属: Human, Drosophila
-
分类: 科研抗体货号: P34700别名: Homeobox protein Nkx-25, Cardiac-specific homeobox, Homeobox protein CSX, Homeobox protein NK-2 homolog E, Nkx2-5, Csx, Nkx-25, Nkx2e应用: WB,IHC,FCM反应种属: Human, Mouse, Rat
-
分类: 科研抗体货号: P34719别名: 2-hydroxyacylsphingosine 1-beta-galactosyltransferase, Ceramide UDP-galactosyltransferase, Cerebroside synthase, UDP-galactose-ceramide galactosyltransferase, UGT8, CGT, UGT4应用: WB反应种属: Human, Mouse, Rat
-
分类: 科研抗体货号: P34699别名: Inactive rhomboid protein 2, iRhom2, Rhomboid 5 homolog 2, Rhomboid family member 2, Rhomboid veinlet-like protein 5, Rhomboid veinlet-like protein 6, RHBDF2, IRHOM2, RHBDL5, RHBDL6应用: WB反应种属: Human, Mouse
-
分类: 科研抗体货号: P34718别名: 2-oxoisovalerate dehydrogenase subunit beta, mitochondrial, Branched-chain alpha-keto acid dehydrogenase E1 component beta chain, BCKDE1B, BCKDH E1-beta, BCKDHB应用: WB,FCM反应种属: Human, Rat
-
分类: 科研抗体货号: P34698别名: Sphingomyelin phosphodiesterase, Acid sphingomyelinase, aSMase, SMPD1, ASM应用: WB,IHC反应种属: Human, Mouse
-
分类: 科研抗体货号: P34715别名: T-cell acute lymphocytic leukemia protein 1, TAL-1, Class A basic helix-loop-helix protein 17, bHLHa17, Stem cell protein, T-cell leukemia/lymphoma protein 5, TAL1, BHLHA17, SCL, TCL5应用: WB,IHC反应种属: Human, Mouse
-
分类: 科研抗体货号: P34696别名: Ornithine decarboxylase antizyme 1, ODC-Az, OAZ1, OAZ应用: WB反应种属: Human, Mouse, Rat

鄂公网安备42018502007531号
鄂公网安备42018502007531号

